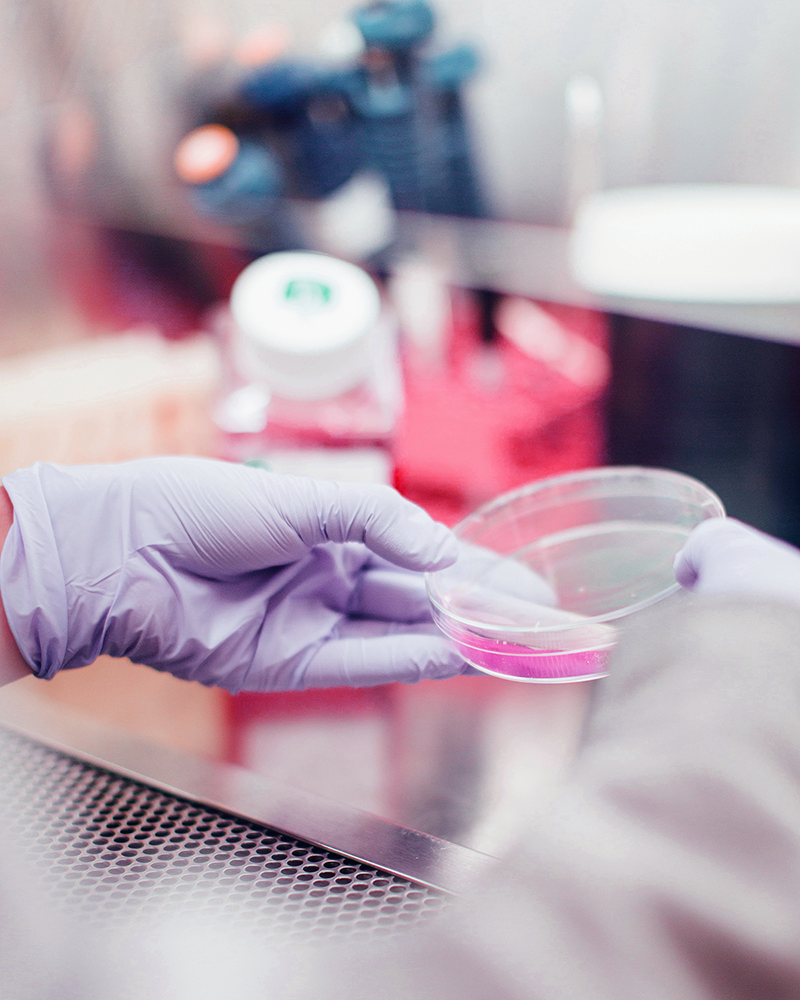
sicence-maqui-berry

Our Process — From Nature to Science
Each MNL GROUP extract tells the story of a rigorous and traceable process — from the harvest of Maqui Berry in Patagonia to its transformation into standardized, clinically validated ingredients trusted worldwide.
From Patagonia’s Forests to Global Science
Our process begins in the wild forests of Southern Chile, where Maqui (Aristotelia chilensis) grows naturally.
Berries are hand-harvested by local families under fair-trade and sustainability principles, ensuring minimal environmental impact and social inclusion.
Every Maqui berry collected carries data, certification, and purpose.

Supply & Logistics Chain
The journey of Maqui from the forest to the laboratory follows a controlled and fully traceable path, supported by specialized partners at every stage.

-
- Seasonal harvest between January and March through verified local suppliers.
- Strategic Partner: Native communities
-
- Storage of fresh Maqui under controlled freezing conditions to preserve anthocyanins.
- Strategic Partner: Certified Frozen Storage
-
- Shipment of frozen Maqui to Europe under strict temperature monitoring.
- Strategic Partner: Agencies & Global Forwarders
-
- Production of Maqui extracts (Delphinol®, MaquiBright®) through patented extraction technology ensuring consistent delphinidin levels.
- Strategic Partner: Anklam Extrakt GmbH
-
- Global distribution through specialized nutraceutical partners.
- Strategic Partner: CK Ingredients (USA & Canada)
Controlled Production & Data Management
Every step of the process is connected through MNL GROUP’s Data Management System, ensuring real-time traceability and transparency across the entire supply chain.
Traceability Model Includes:
• Collection data (origin, harvest date, batch ID).• Logistics records (temperature, transit time, storage conditions).
• Extraction parameters and standardization metrics (≥35 % anthocyanins, ≥25 % delphinidins).
• Quality assurance reports and analytical certificates.
From biomass to bioactive extract, every variable is measured, recorded, and verified.
Data Transfer & Full Traceability
Our digital traceability platform integrates suppliers, logistics operators, and laboratories in a single data stream.
This system enables:
Continuous Data Transfer
from field to production.
Audit-ready documentation
for each batch.
Scientific reproducibility
for regulatory and clinical use.

Quality & Scientific Verification
- HPLC fingerprinting for anthocyanin quantification.
- ORAC 5.0 for antioxidant capacity measurement.
- Microbiological, heavy metal, and pesticide screening.
- Toxicological evaluation and stability testing.
Certified Partners & Global Standards
Our entire process adheres to GMP, ISO 9001, and HACCP standards and complies with international safety and environmental regulations.
We also work within the UEBT framework for responsible sourcing (Field Verification Programme 2025–2026), ensuring that our Maqui supply chain is socially, economically and environmentally responsible.
No consumer-facing claims or logos are used pending further verification stages.
Continuous Improvement & Innovation
- New extraction methods to maximize delphinidin bioavailability.
- Expanded Maqui cultivation for reduced wild harvest pressure.
- Digital traceability and blockchain-based certification for supply chain transparency.
Partner with the Leaders in Maqui Berry Science
Discover how our standardized Maqui extracts can elevate your formulations with clinically validated antioxidant power.
